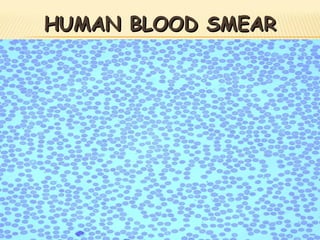
HUMAN BLOOD SMEAR
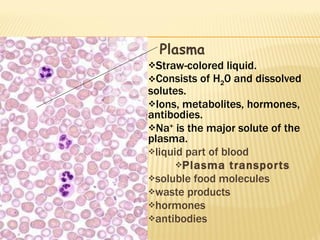
Plasma Straw-colored liquid. Consists of H 2 0 and dissolved solutes. Ions, metabolites, hormones, antibodies. Na +  is the major solute of the plasma. liquid part of blood Plasma transports soluble food molecules waste products hormones  antibodies

The human body contains approximately 5 liters of blood composed of plasma and cellular elements. Plasma is 55% of blood and contains water, proteins, electrolytes, and other substances. Cellular elements include red blood cells containing hemoglobin, white blood cells for immunity, and platelets for clotting. Blood transports oxygen, nutrients, wastes, hormones, and more throughout the body.